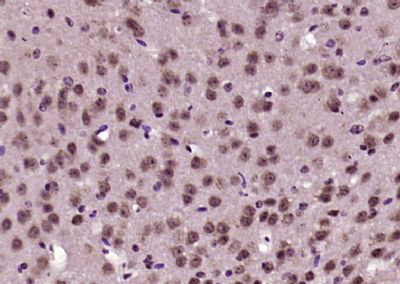
产品细节图片1

相关产品推荐更多 >
万千商家帮你免费找货
0 人在求购买到急需产品
- 详细信息
- 文献和实验
- 技术资料
- 供应商:
江西江蓝纯生物试剂有限公司
- 库存:
91
- 克隆性:
单克隆
- 保质期:
1年
- 抗体英文名:
IKAP
- 抗体名:
IKK复合物相关蛋白抗体
- 适应物种:
人/动物/植物
- 应用范围:
WB,ELISA等
- 浓度:
1mg/ml
- 保存条件:
-20 °
- 规格:
100ul/200ul
| 规格: | 100ul | 产品价格: | ¥1580.0 |
|---|---|---|---|
| 规格: | 200ul | 产品价格: | ¥2480.0 |
英文名称 : IKAP
中文名称 : IKK复合物相关蛋白抗体
别 名 : DKFZp781H1425; DYS; Dysautonomia (Riley Day syndrome hereditary sensory autonomic neuropathy type III); Elongator complex protein 1; ELP 1; ELP1; ELP1_HUMAN; FD; FLJ12497; IKAP; IkappaB kinase complex associated protein; IkappaB kinase complex-associated protein; ikbkap; IKI 3; IKI3; IKK complex associated protein; IKK complex-associated protein; Inhibitor of kappa light polypeptide gene enhancer in B cells kinase complex associated protein; OTTHUMP00000063889; p150; TOT 1; TOT1
研究领域 : 心血管 细胞生物 神经生物学 信号转导 激酶和磷酸酶 表观遗传学
抗体来源 : Rabbit
克隆类型 : Polyclonal
交叉反应 : Human, Mouse, Rat, Rabbit,
产品应用 : WB=1:500-2000 ELISA=1:500-1000 IHC-P=1:400-800 IHC-F=1:400-800 ICC=1:100-500 IF=1:100-500 (石蜡切片需做抗原修复)
not yet tested in other applications.
optimal dilutions/concentrations should be determined by the end user.
分 子 量 : 150kDa
细胞定位 : 细胞核 细胞浆
性 状 : Lyophilized or Liquid
浓 度 : 1mg/ml
免 疫 原 : KLH conjugated synthetic peptide derived from human IKAP:1151-1250/1332
亚 型 : IgG
纯化方法 : affinity purified by Protein A
储 存 液 : 0.01M TBS(pH7.4) with 1% BSA, 0.03% Proclin300 and 50% Glycerol.
保存条件 : Store at -20 °C for one year. Avoid repeated freeze/thaw cycles. The lyophilized antibody is stable at room temperature for at least one month and for greater than a year when kept at -20°C. When reconstituted in sterile pH 7.4 0.01M PBS or diluent of antibody the antibody is stable for at least two weeks at 2-4 °C.
PubMed : PubMed
产品介绍 : The transcription factor NFkB is retained in the cytoplasm in an inactive form by the inhibitory protein IkB. Activation of NFkB requires that IkB be phosphorylated on specific serine residues, which results in the targeted degradation of IkB (1). IkB kinase alpha (IKK alpha), previously designated CHUK (2), interacts with IkB-alpha and specifically phosphorylates IkB-alpha on the sites that trigger its degradation, serines 32 and 36 (3). IKKalpha appears to be critical for NFkB activation in response to proinflammatory cytokines (4). Phosphorylation of the IkB by IKK alpha is stimulated by the NFkB inducing kinase (NIK), which itself is a central regulator for NFkB activation in response to TNF and IL-1 (5). The functional IKK complex contains three subunits, IKK alpha, IKK beta and IKK gamma (also designated NEMO), and each appears to make essential contributions to IkB phosphorylation (6). IKAP (IKK-complex-associated protein) is a protein that acts as a scaffold, interacting with NIK, IKK alpha and IKK beta and assembling them into an active kinase complex (7,8)
Function:
May act as a scaffold protein that may assemble active IKK-MAP3K14 complexes (IKKA, IKKB and MAP3K14/NIK).
Acts as subunit of the RNA polymerase II elongator complex, which is a histone acetyltransferase component of the RNA polymerase II (Pol II) holoenzyme and is involved in transcriptional elongation. Elongator may play a role in chromatin remodeling and is involved in acetylation of histones H3 and probably H4.
Subcellular Location:
Cytoplasm. Nucleus.
DISEASE:
Defects in IKBKAP are the cause of hereditary sensory and autonomic neuropathy type 3 (HSAN3) [MIM:223900]; also known as Riley-Day syndrome or familial dysautonomia (FD). This autosomal recessive disorder is due to the poor development and survival, and progressive degeneration of the sensory, sympathetic and parasympathetic neurons. HSAN3 individuals are affected with a variety of symptoms such as decreased sensitivity to pain and temperature, cardiovascular instability, recurrent pneumonias, vomiting crises, and gastrointestinal dysfunction. It is primarily confined to individuals of Ashkenazi Jewish descent, with an incidence of 1/3'600 live births.
Similarity:
Belongs to the ELP1/IKA1 family.
SWISS:
O95163
Gene ID:
8518
Important Note:
This product as supplied is intended for research use only, not for use in human, therapeutic or diagnostic applications.
产品图片
风险提示:丁香通仅作为第三方平台,为商家信息发布提供平台空间。用户咨询产品时请注意保护个人信息及财产安全,合理判断,谨慎选购商品,商家和用户对交易行为负责。对于医疗器械类产品,请先查证核实企业经营资质和医疗器械产品注册证情况。
 文献和实验
文献和实验);circulating immune complexes(CIC) 近年来随着医学免疫学的发展,有关病原体引起的免疫反应及其免疫复合物对人体健康的影响日益受到关注,有关循环免疫复合物对心脑血管的损害以及对脑血管疾病的发生与发展是否有相关性也受到高度重视。本文对脑梗死140例患者血中巨细胞病毒抗体(CMV-IgG与CMV-IgM)与肺炎衣原体抗体(CP-IgG)进行了分析,提示这些因素对脑梗死的发生、发展与病情稳定及康复之间存在一定的关系。 一、研究对象选择 1、研究对象 选择珠海市人民医院神经内科2006
三句话读懂一篇 CNS:节食减肥为何容易反弹?中国团队揭开背后原因 | 吸烟增加 56 种疾病发生风险
,中国科学院上海营养与健康研究所秦骏、中山大学黄海及陆军军医大学江军等团队合作在 Nature Communications 杂志发表研究论文 ARID1A loss induces polymorphonuclear myeloid-derived suppressor cell chemotaxis and promotes prostate cancer progression。 该研究发现 ARID1A 是 SWI/SNF 染色质重塑复合物的一个亚基,在炎症诱导的 IKKβ 激活的下游
-κB 下游的细胞因子和驱化因子。 进一步,研究者通过免疫印迹和免疫组化分析证实,肝细胞 Miz1 的缺失促进 IKK 介导的 MTDH 的磷酸化,从而促进了 NF-κB 的激活和 NF-κB 下游炎症相关靶基因的表达。 (3)肿瘤特有肝细胞分泌细胞因子促进肿瘤浸润巨噬细胞向促炎表型转化 对巨噬细胞亚群和肝脏特有巨噬细胞(Kupffer cell)进一步细分,并进行差异基因分析和 Qusage 分析,发现 Miz1∆hep 小鼠的肿瘤浸润巨噬细胞和 Kupffer 细胞的一些亚群 NF-κB 强烈











